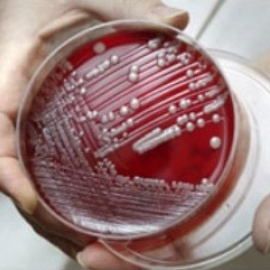
Cepa de "superbacteria" SARM resistente a los antibióticos

-
Sociedad -
"Esquizofrenia u homosexualidad afeminada": los apuntes tránsfobos de Medicina en la Universidad Complutense

-

-

-
Sociedad -
Los estudiantes de Medicina de la URJC se alzan en pleno escándalo Cifuentes contra una "decisión clasista de la universidad"

-
 Publicidad
Publicidad -

-
Ciencias -
La cirugía de la epilepsia es la opción de los pacientes que no responden a la terapia con fármacos

-

-

-
 Publicidad
Publicidad -
Sociedad -
El efecto secundario del ‘medicamentazo’: la mitad de los fármacos se encarecen desde que son de pago

-

-

-

-
 Publicidad
Publicidad -

-

-
-


